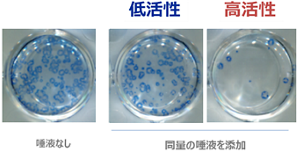
唾液自体の抗インフルエンザ効果にも違いがある。プラーク定量法により、「ほとんど感染を起こさない唾液」と「多くの細胞が感染してしまう唾液」があることが明らかになった。

イノベーションのDNA

【特集:インフルエンザ】
あなたを守る「上気道バリア機能」の秘密(前編)

今年も例年を上回るインフルエンザ感染拡大の傾向に、警戒感が強まっている。とにかく、インフルエンザにかかると、つらい。なんとかインフルエンザウイルスから身を守ることはできないか。
頑張る一人ひとりを守ることで、感染に強い社会を実現したい──そんな願いから始まった研究がインフルエンザ対策に新たな可能性をもたらした。
あなたの周りにも、風邪やインフルエンザに「かかりにくい人」に心当たりはないだろうか。
実はインフルエンザにかかりにくい人には、本人も自覚しにくい「秘密」があったのだ。
その新事実の解明に挑んだ花王の研究成果を前後編の2回に分けて紹介する。
受験生をはじめ、今だけは絶対にかかりたくない! と切なる願いを抱えている人も多いはずだ。こんな時、自分にもっと体力があれば……と思うが、実はアスリートでさえも、過度なトレーニング後の数日間は体調を崩しやすいことが知られている。
2019年9月に開催された花王ヘルスケアフォーラムでは、スポーツ医学、運動免疫学を専門とする国立スポーツ科学センターの枝伸彦氏が「高疲労・高ストレスが招く免疫機能低下と感染症予防」と題し、基調講演を行った。受験や試合など大事な時を控える人など「高疲労・高ストレスの人は、特に免疫機能の低下に注意が必要です」と指摘している。
2018~19年にかけて花王が行った調査からも、疲労とストレスの度合いが高い人ほど、風邪やインフルエンザに感染しやすいことが示された。そう、今、頑張っている人ほど要注意かもしれないのだ。そこで今回はインフルエンザ予防策の新たな一手として、「上気道バリア機能」の本来の働きを引き出す“秘策”を紹介していく。

おそらく、この記事を読まれている方は、日頃から予防に対する意識も高いのではないだろうか。手洗い、うがい、マスクに加湿器。子育て中の筆者もかなり警戒して気を付けている。
だが、そんな我々にとって、にわかには信じがたいデータがある。なんと「インフルエンザにかかりやすい人(群)には、かかりにくい人に比べて予防を多く行っている人が多い」というのだ。

「えーっ、今までの努力は無駄だったの?」と叫びたくなるところだが、この結果の捉え方としては、どうも違うようだ。花王 パーソナルヘルス研究所の山本真士氏は次のように話す。
「これらの予防行動に効果がないということではなく、それでもかかってしまうほど、インフルエンザのかかりやすさには『個人差』があるものと考えられます。この結果は社内でも物議を醸したのですが、かかりやすい自覚がある人ほど、予防に力を入れているのだと捉えられます」

花王ではこの調査の前段として、まず約1万9577人を対象とした調査をしている。ここでは「過去1年間に一度も風邪にかからず、過去3年間にインフルエンザにもかかっておらず、なおかつ感染症にかかりにくい自覚がある人」を「かかりにくい人」とし、反対に「過去1年間に3回以上風邪をひき、過去3年間に2回以上インフルエンザにかかり、なおかつ感染症にかかりやすい自覚がある人」を「かかりやすい人」とする基準を設けた。
その結果、「かかりにくい」に該当する人は、33%(6491人)、「かかりやすい」に該当する人は2%(405人)、どちらの条件にも該当しない中間層が65%を占めた。
図1と図2の調査は、この大規模調査で抽出された109名(前出の33%と2%に該当する人から選抜)を対象に実施し、前出の「インフルエンザにかかりやすい人(群)には、かかりにくい人に比べて予防を多く行っている人が多い」というのは、予防行動について詳しいヒアリングを行った結果だ。
繰り返しになるが、既存の予防法を否定するものではないことは重ねて強調しておきたい。厚生労働省やアメリカ疾病管理センター(CDC)が科学的な根拠があるものとして、ワクチンの接種、手洗い、咳エチケット(咳やくしゃみをする際に、マスクやティッシュ・ハンカチ、袖を使って、口や鼻をおさえること)を推奨している。また、インフルエンザのワクチンについては「重症化を防ぐ」意味合いが大きいこと(※2)、うがいによる予防効果はインフルエンザについては科学的に証明されていないこと(※3)も追記しておきたい。
さて、これだけ気をつけていても、依然としてインフルエンザが大きな脅威であることに変わりはない。厚生労働省によると、季節性インフルエンザの国内感染者数は年間で約1000万人と推定され、10人に1人が感染するといわれている。その数はいっこうに減る傾向にない。

こうした現状を前に立ち上がったのが、花王の研究者集団だ……! と言いたいところなのだが、最初はほんの数人の小さなチームだったという。そもそも「トイレタリーメーカーが、なぜインフルエンザ?」と不思議に思う人もいるかもしれない。
「もともと花王には、清潔・美・健康・環境という大きく4つの研究領域があります。その中間領域に、まだ取り組むべき課題があるのではないかということで、清潔と健康の間にある『衛生』領域に着眼することになりました。私は当時、ヘルスケア食品研究所に所属していたのですが、生物科学研究所、パーソナルヘルスケア研究所、それから事業部の人たちと一緒にアイディアを出し合っていく中で、公衆衛生の大きな問題であるインフルエンザに対して、独自のアプローチができないかという話になりました」(山本氏)
こうしてプロジェクトが始動したのが2015年。この時点では「抗インフルエンザ性」を示す有効成分の手がかりは、まったくと言っていいほどなかった。インフルエンザのかかりやすさに「個人差がある」といっても、あまりにも漠然としているが、その所以をどのように解明していったのか。
研究チームが注目したのは「感染が成立するまで」の過程だ。インフルエンザは接触感染、飛沫感染、さらには空気感染が成立する。ウイルスとの接触を回避するのは、ほぼ不可能だろう。ならば、どうにか感染を瀬戸際でくい止めることはできないか。
「感染」とは、口や鼻、あるいは目の粘膜から体内に侵入したウイルスが細胞の中で増殖する状態を指す。主戦場となるのは「上気道」(鼻から鼻腔、副鼻腔、咽頭、喉頭まで)の粘膜だ。

当然、我々の体もみすみす敵の侵入を許しているわけではない。たとえば、唾液や鼻汁などに多く含まれる分泌型IgA(secretory immunoglobulin A; SIgA)は、粘膜免疫で中心的な役割を果たしている抗体だ。また血液中のIgG抗体も、ウイルスに対する感染防御に効果の高い抗体として知られている。(現在の注射型ワクチンは、主にIgG抗体を誘導するもので、血中から気道粘膜にしみでる抗体により感染が抑制されると考えられている。しかし、現行ワクチンでは分泌型IgA抗体を誘導できないため、感染の防御には限界がある。(※5)

こうした免疫機能の活性化を図るアプローチは、世界中で盛んに研究が続けられており、免疫のバリア機能に対する人々の関心も高い。だができれば、免疫部隊の出番を必要とする前に、もう一つ手前の段階で何かできないか。そう考えたのが花王の研究チームだった。
「免疫機能を高めることは非常に重要です。しかし、免疫に加えて何かできないか?と考えました。そこで粘膜上皮細胞にウイルスが到達するか、しないか、その瀬戸際に注目しました。それが『上気道粘膜上皮バリア機能』(以下、『上気道バリア機能』)です」と山本氏は話す。
「上気道バリア機能」とは唾液、粘液、繊毛における一連の生理機能を指している。たとえば、気管支に入り込んだウイルスなどの異物は、粘膜上皮細胞から分泌される粘液にキャッチされ、繊毛運動によって排出されることが知られている。ただし繊毛には寒さと乾燥に弱いという残念な弱点もある。

また、プロジェクトの開始当初(2015年頃)は、世界的にみても「上気道バリア機能」とインフルエンザのような上気道の感染症との関連についての学術論文は少なく、一般的にそれらは体を守る働きがあると言われているものの、その重要性を裏付けるデータが十分にあるとは言えなかった。
しかし、その中でも例外があった。唾液である。唾液に含まれる複数の成分がインフルエンザウイルスの防御に寄与する可能性(※6)を含め、いくつか報告があったため、山本氏らは、唾液に焦点を絞って研究を進めることにした。
具体的には、まず唾液の量を調べた。前出の「かかりにくい人」「かかりやすい人」(計109名)から、安静にした状態で唾液を採取。2分ごとに5回、唾液を採取し、全体の重量を比較した。その結果、インフルエンザにかかりやすい人は、かかりにくい人に比べて、有意に唾液の分泌量が少ないことが示された。

つまり、唾液の量が多いほうがかかりにくい可能性があるということだ。ならば、やはり唾液の中に、感染防御にはたらく成分がありそうだ。そこで次に唾液の「質」に注目した実験がなされた。
複数の人から唾液を採取し、それぞれ一定量をA型インフルエンザウイルスと混合した上で、実験用の培養細胞(※7)に感染させた。その後、「プラーク定量法」と呼ばれる方法でインフルエンザウイルスを可視化することにより、ウイルスの培養細胞への感染の程度を調べることができる。すると、同じ量の唾液を混合しても「ほとんど感染を起こさない唾液」と「多くの細胞が感染してしまう唾液」があることが明らかになった。
つまり、単に唾液がたくさん出ればいい、というだけではなかったのだ。ここにインフルエンザのかかりやすさにおける“個人差”の理由がありそうだ。唾液の「抗インフルエンザ効果」のカギを握る物質とは何なのか。そして、「質の良い唾液」にするにはどうしたらよいのか。
つつぎは<後編>へ。
powered by ブルーバックス
※1 厚生労働省 労働者の疲労蓄積度チェックリスト
https://www.mhlw.go.jp/topics/2004/06/tp0630-1.html
※2 厚生労働省 インフルエンザQ&A
https://www.mhlw.go.jp/bunya/kenkou/kekkaku-kansenshou01/qa.html
※3 首相官邸インフルエンザ(季節性)対策
https://www.kantei.go.jp/jp/headline/kansensho/influenza.html
※4 薬局サーベイランス
http://prescription.orca.med.or.jp/syndromic/yakkyoku/#h3_001_1
※5 モダンメディア61巻10号2015[免疫]インフルエンザスプリットワクチンの限界と新規ワクチンの開発
http://www.eiken.co.jp/modern_media/backnumber/pdf/MM1510_01.pdf
※6 White, MR; Helmerhorst, EJ; Ligtenberg, A; Karpel, M; Tecle, T; Siqueira, WL; Oppenheim, FG; Hartshorn, KL. Multiple components contribute to ability of saliva to inhibit influenza viruses. Oral Microbiology Immunology 2009, 24, 18–24.
※7 MDCK細胞(イヌ腎臓尿細管上皮細胞由来の細胞株)。様々な研究用途に最も広く使用されている細胞株の1つ。